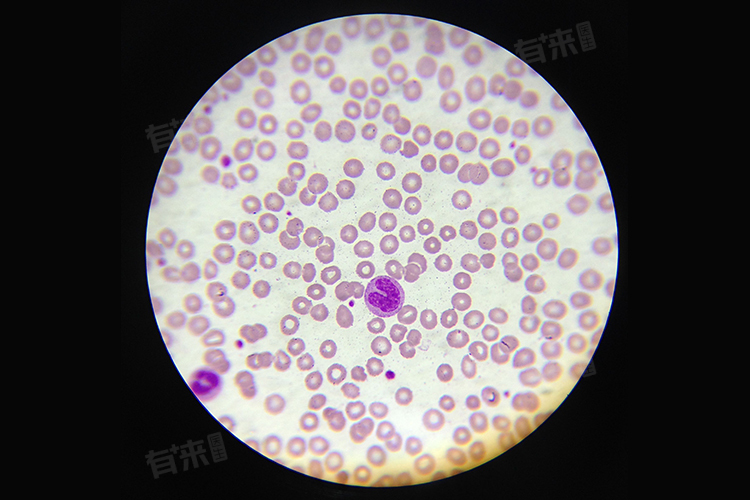

白细胞高通常表明体内存在炎症反应,但具体炎症发生的部位并不是固定的,因为全身多个系统或器官都有可能发生炎症,进而引起白细胞数量的升高,常见炎症部位为呼吸系统、消化系统等。
1、呼吸系统:如肺部炎症,包括各种细菌、病毒引起的肺部感染,如肺炎、支气管炎等。这些炎症会刺激机体产生免疫反应,导致白细胞数量增加,以抵御病原体的侵袭。
2、消化系统:腹腔内的脏器如胃、肠、肝、胆等发生感染时,也会引起白细胞升高,常见的疾病包括急性胃肠炎、胆囊炎等。
3、泌尿系统:泌尿道感染,如膀胱炎、尿道炎、肾盂肾炎等,也是导致白细胞升高的常见原因。这些炎症通常伴有尿频、尿急、尿痛等尿路刺激症状。
4、生殖系统:对于男性和女性而言,生殖系统的炎症也可能引起白细胞升高。如女性子宫颈炎、阴道炎,以及男性前列腺炎等。
5、神经系统:脑部炎症,如化脓性脑膜炎、脑炎等,同样会导致白细胞升高。这些炎症往往伴有发热、头痛、呕吐等神经系统症状。
白细胞升高还可能与其他系统的炎症有关,如皮肤感染、骨骼感染等。一些非感染性疾病也可能导致白细胞升高,如急性大出血、急性中毒、白血病、恶性肿瘤等。这些情况下,白细胞升高往往与原发疾病的严重程度密切相关。
当发现白细胞升高时,应结合患者的临床症状、体征以及其他实验室检查结果进行综合判断。必要时可进行影像学检查(如CT、B超等)以明确炎症发生的具体部位和性质。在治疗上,应针对病因进行抗感染治疗或针对原发疾病进行治疗。同时,注意保持患者的水电解质平衡和营养支持,以促进疾病的恢复。

